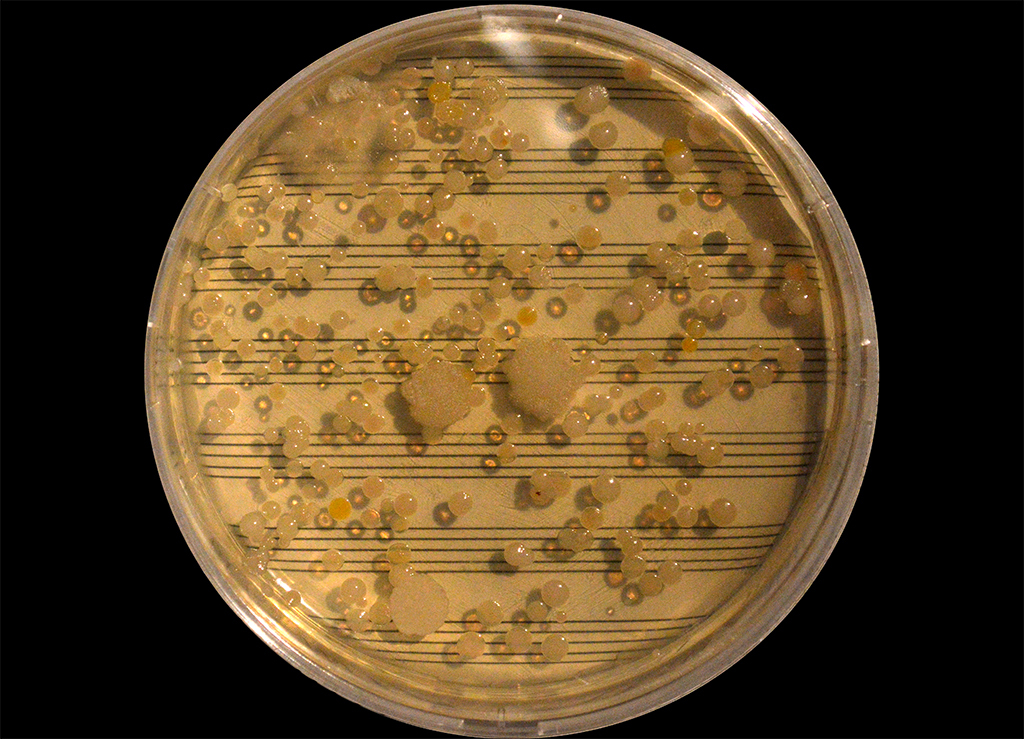

![]()
Hay un árbol muerto cerca de mi estudio aquí en ÖRES, Finlandia, que tiene una grieta enorme en su tronco y está completamente hueco por dentro. Mientras lo dibujo, me pregunto: ¿a qué sonará ese vacío? Para saberlo, he superpuesto una cuerda -de arpa- sobre su agujero como si este fuera la boca de un instrumento musical, y al hacerla vibrar resuena todo eso que ya no está (Véase y escúchese el video, el sonido es real)


Vídeo:

Esta obra -ya adquirida- está cambiando de color, del verde al marrón amarillento, debido a que las hojas están perdiendo la clorofila. Mi idea es que al final sea como una joya orgánica dorada, que el oro sea el tiempo y el arte una forma de lidiar con el cambio, de tocar lo que ya no está 
De la serie «THE EMERGENCE OF LIFE». Un Proyecto realizado con el apoyo del programa de ayudas a la creación y la movilidad del Ayuntamiento de Madrid.
Video:
![]()
He estado recogiendo ramas enfermas de los distintos árboles que hay en Genalguacil Pueblo Museo, guardándolas cuidadósamente entre las páginas de algodón de un libro a modo de expedición botánica; Después, he traducido los agujeros y puntos de infección de las hojas de cada rama a una caja musical, dando como resultado una composición formada por 43 partes (correspondiendes a 43 ramas)
Aquí dejo una pequeña muestra sonora y visual, la obra completa podrá verse, tocarse y escucharse durante la expo que inauguraré el próximo año en su Museo de Arte Contemporáneo.Porque los árboles también enferman.


Deja un comentario